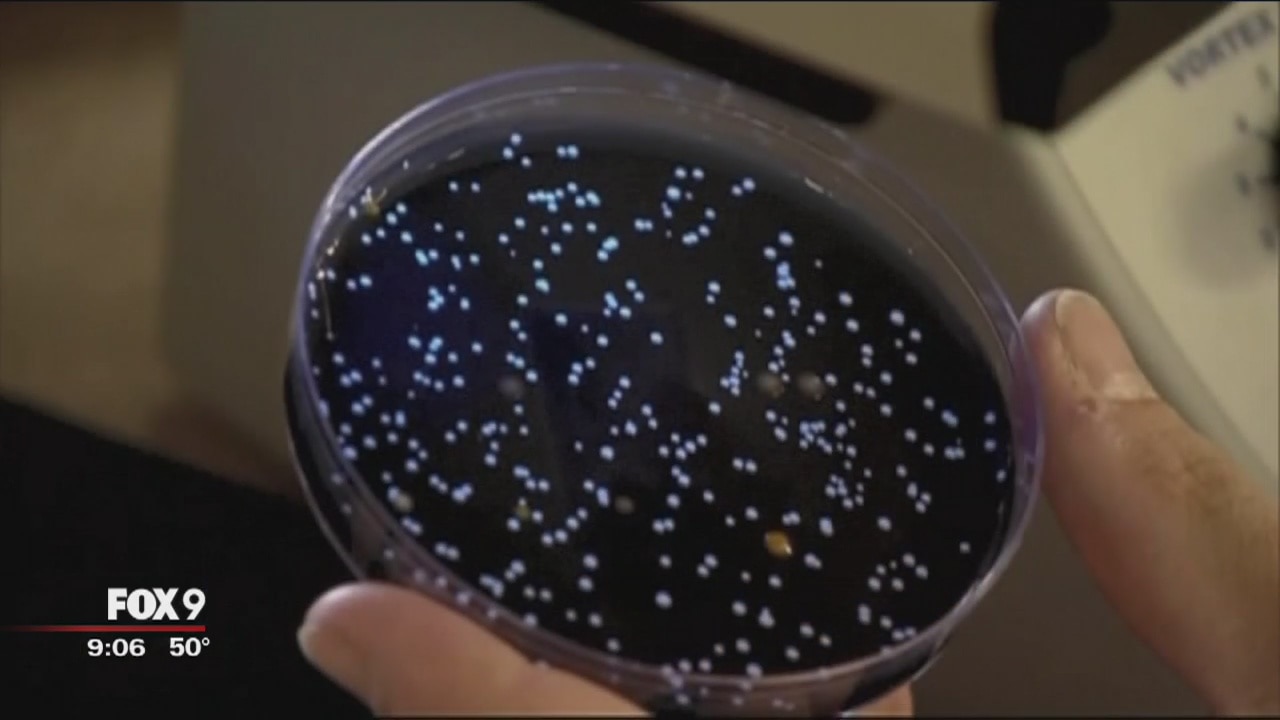

Hopkins Legionnaires' update: 20 confirmed cases
The Minnesota Department of Health has confirmed 3 additional cases of Legionnaires? disease in the Hopkins outbreak, bringing the total to 20. The 20 cases still include just one death, and 16 people have been hospitalized.

